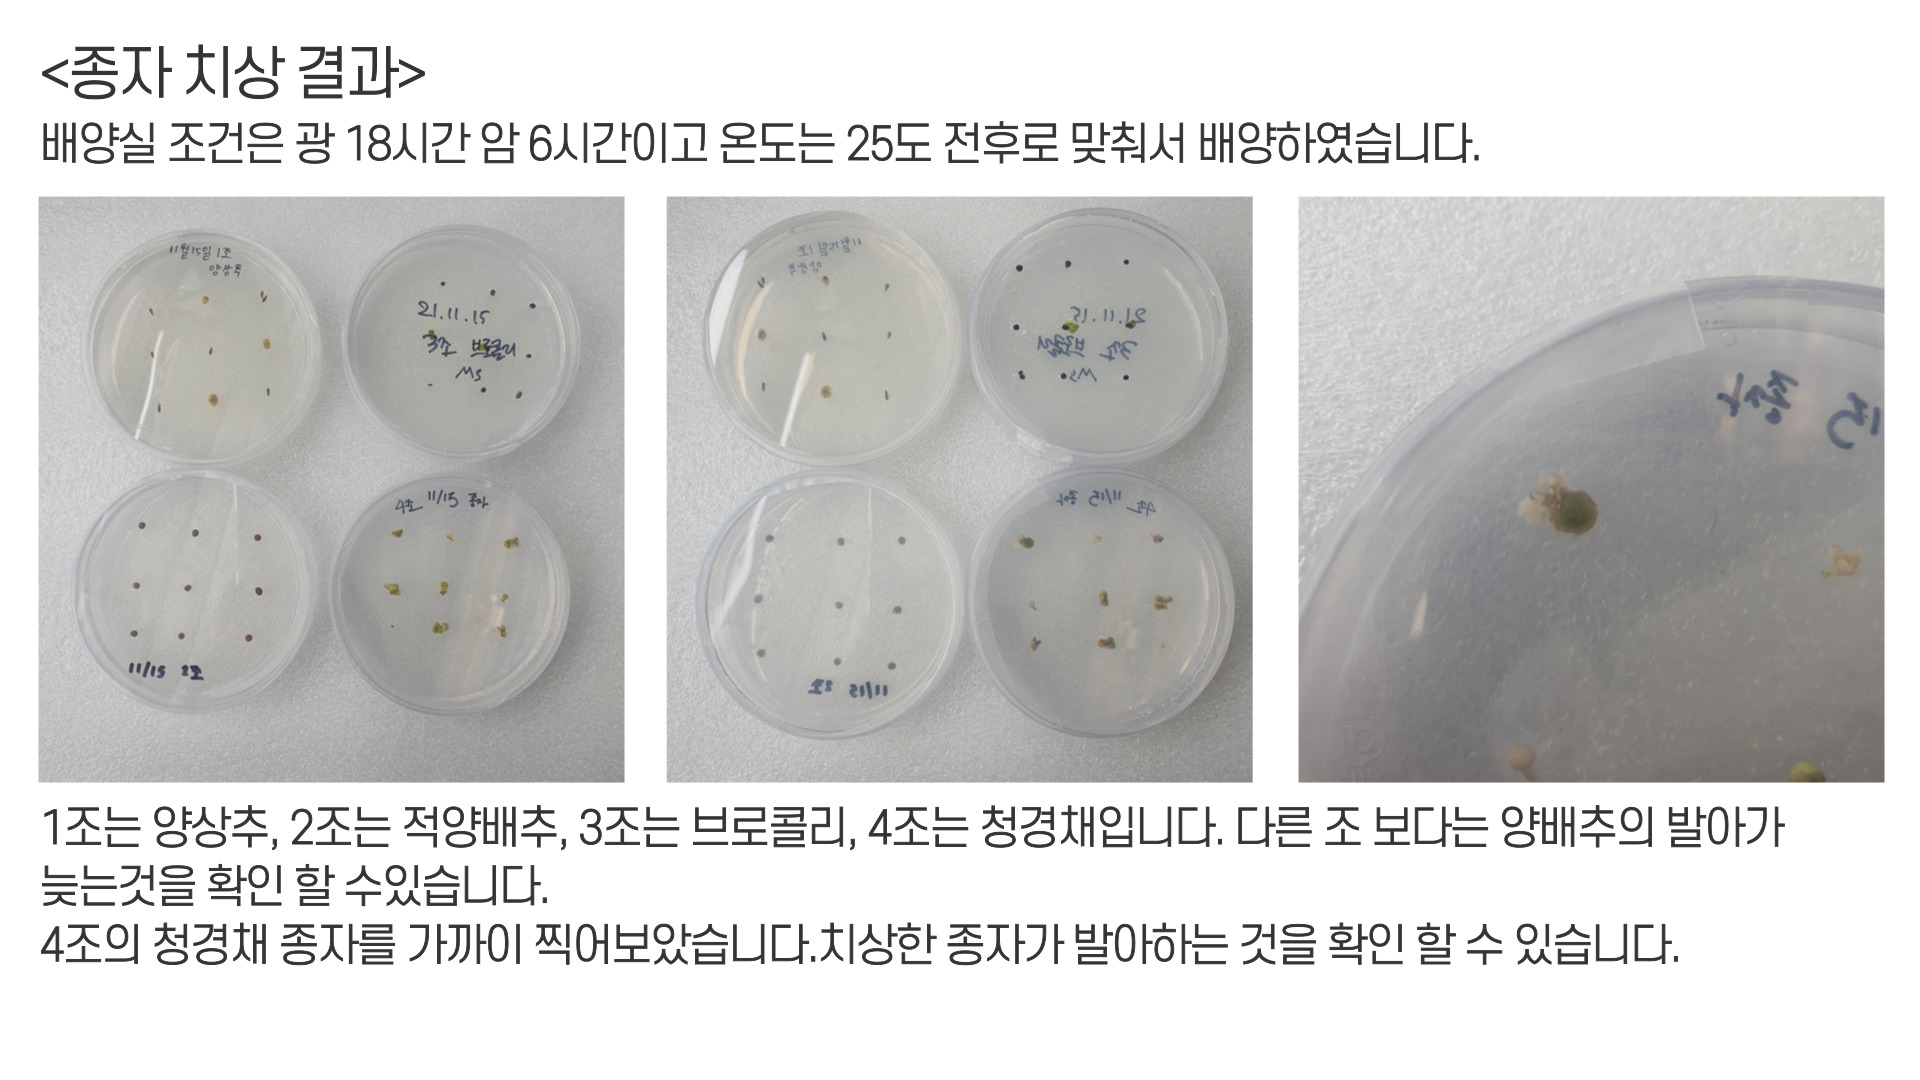

대학교에서 실습한 MS 배지에
적양배추 종자를 치상하는 방법과
준비물에 대하여 알아보겠습니다.
관심있으시는 모든 학생분들에게 도움이 되었으면 좋겠습니다.
MS배지와 관련된 내용은 전 블로그에 있으니
참고 부탁드립니다.
MS배지 만들기, 고체 MS배지 만드는 과정 및 준비물 고구마 치상 실험용 배지 & 피펫 팁 사용법
대학교에서 실습한 MS배지 만드는 과정과 MS배지 준비물에 대해서 알아보겠습니다. 이번 실습에는 고체형 MS배지를 만드는 과정을 적어보겠습니다. 관심있으시는 모든 학생분들에게 도움이 되었
pparksaeda.tistory.com

적양배추 치상 준비물 입니다.
정확하게 적어보고 싶어서 실험에 사용된 모든 준비물을
사진을 찍어 올려보았습니다.
| 메스, 메스대, 집게 | 재료의 조제나 이식과 절단에 사용 |
| MS배지 | 적양배추 종자를 치상하기 위한 용도 |
| 멸균수와 락스 4% | 양배추 종자를 넣어 세척하는 용액 |
| 적양배추 종자 | |
| 1.5ml 튜브 | 양배추 종자를 넣어 세척하는 용기 |
| 메스실린더 | 정확한 배지의 정량을 맞추기 위함 |
| 피펫 | 호르몬 첨가시 정확한 양 조절 |

적 양배추 30개 정도를 1.5ml 튜브에 담아 피펫으로
락스4%0.6ml와 증류수 0.6ml를 첨가하여
5분동안 세척해 주었습니다. (그렇다면 1.2ml 락스 2%)
적양배추 종자의 크기는
다른 조의 종자의 크기보다 크기때문에 많이 들어가지 않습니다.
락스로 세척한 1.5ml와 손을 알콜 70%를 뿌려준 뒤에
클린벤치로 들어가 작업합니다.

피펫을 이용하여 1.5ml에 담아져있는 세척용액을 꺼내주고
멸균수를 1ml를 넣어줍니다.
(3분동안 세척을 3번 해줍니다.)

핀셋을 화염소독 해주고 1.5ml 안에 있는 종자를 하나씩 꺼내어
MS배지에 9개씩 치상해 줍니다.
(화염소독한 핀셋이 뜨거울 수도 있으니 상층용액에 식힌 후에 꺼내줍니다.)
양배추 종자를 치상해서 다른 조 보다는 수월하게 치상하였습니다.
양배추 종자는 다른 조의 종자보다 일주일 더 늦게 발아합니다.
<당시 조의 종자 상황>
1조 양상추
3조 브로콜리
4조 청경채
종자 치상이 끝난 페트리디쉬는
파라필름으로 밀봉한 후에 배양실로 옮겨줍니다.
(배양실 조건 : 광 18시간 암 6시간 , 온도 25도 전후)
배양실 조건은 광 18시간 암 6시간이고
온도는 25도 전후로 맞춰서 배양하였습니다.
4조의 청경채 종자를 가까이 찍어보았습니다.
치상한 종자가 발아하는 것을 확인 할 수 있습니다.
고구마 끝순 채취와 고구마 생장점 배양과 치상 준비물 및 방법
대학교에서 실습한 고구마 끝순 채취와 고구마 생장점 배양과 치상 준비물 및 방법에 대해 알아보겠습니다. 관심있으시는 모든 학생분들에게 도움이 되었으면 좋겠습니다. 고구마 생장점 배양
pparksaeda.tistory.com
초록색? 빨간색? 청피망,홍피망 아삭아삭 몸에 좋은 피망!! 피망의 효능과 부작용에 대해 알아보
비타민의 보물 피망!! 오늘은 고추를 개량하여 매운맛을 줄이고 아삭한 식감을 살린 피망의 효능과 부작용에 대해 알아보도록 하겠습니다. 튼튼한 눈 건강 : 비타민 A가 많고 비타민 A의 전구체
pparksaeda.tistory.com
'작물 > 채소학 실험실' 카테고리의 다른 글
| B5배지, B-5배지 만들기 식물조직배양에 가장 많이 사용하는 배지 만드는 과정 및 준비물 (0) | 2023.08.11 |
|---|---|
| NLN배지 만들기, 멤브레인 여과기로 NLN배지 만드는 과정 및 준비물 (0) | 2023.08.11 |
| 당근 캘러스 유기 실험, 당근 캘러스 배양 실험 준비물 및 방법 (carrot callus) (5) | 2023.06.18 |
| MS배지 만들기, 고체 MS배지 만드는 과정 및 준비물 고구마 치상 실험용 배지 & 피펫 팁 사용법 (1) | 2023.06.09 |
| 고구마 끝순 채취와 고구마 생장점 배양과 치상 준비물 및 방법 (2) | 2023.06.06 |
댓글